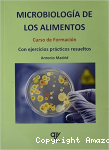
Microbiología de los alimentos vignette

Universidad Nacional del Altiplano
Sistema de Bibliotecas al servicio de la comunidad universitaria
Centro de Recursos para el Aprendizaje
Infraestructura moderna al servicio de la investigación
Espacios para el Estudio e Investigación
Ambientes cómodos y equipados para nuestros estudiantes
Lago Titicaca, Patrimonio Cultural
La universidad más importante del altiplano peruano
Biblioteca Virtual y Repositorio Institucional
Accede a tesis, libros electrónicos y bases de datos académicas
Fachada de la Biblioteca Central UNAP
Más de 120,000 títulos disponibles en nuestras colecciones
Colecciones Especializadas
Libros, revistas y material de consulta para todas las áreas del conocimiento
Edificio Central Universitario
Formando profesionales desde 1856
Biblioteca Central UNAP
Un espacio emblemático de nuestra universidad
Personal del Sistema de Bibliotecas
Profesionales comprometidos con el servicio a la comunidad
Islas Flotantes de los Uros
Preservando la riqueza cultural del altiplano
Microbiología de los alimentos : curso de formación con ejercicios resueltos [texto impreso] / Antonio Madrid, Autor . - Primera edición . - Madrid : AMV Ediciones, 2021 . - 229 páginas : ilustraciones, diagramas, tablas ; 24 cm.
ISBN : 978-84-12-23947-8 Idioma : Español (spa)
| ![]() |
Reserva
Reservar este documentoEjemplares (3)
| Código de barras | Signatura | Tipo de medio | Ubicación | Sección | Estado |
|---|---|---|---|---|---|
| 39248-90224-01 | 664.001579 M14 | Libros | Biblioteca Central | Area Ingenierías ( 1er. Piso ) | Disponible |
| 39248-90225-02 | 664.001579 M14 | Libros | Biblioteca Central | Area Ingenierías ( 1er. Piso ) | Disponible |
| 39248-90913-03 | 664.001579 M14 | Libros | Biblioteca Sede Azángaro | Estanteria (Libros) | Disponible |